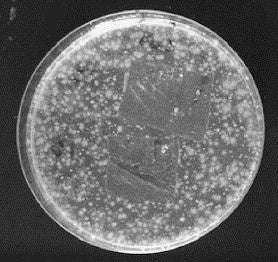

セルロースナノファイバー「ステラファイン(STELLAFINE)」に抗菌性
丸住製紙株式会社と北見工業大学との共同研究によってCNF初となる抗菌性能を確認
丸住製紙株式会社(本社:愛媛県四国中央市、代表取締役社長:星川 知之)が独自の化学変性技術を用いて開発したセルロースナノファイバー(以下、「CNF」)「ステラファイン」が『抗菌性を持つCNF』であることが、国立大学法人北海道国立大学機構北見工業大学(所在地:北海道北見市、学長:鈴木 聡一郎、以下「北見工大」)吉田孝特任教授の研究グループとの共同研究によって確認されました。
これまでに銀イオンや銅イオンなどを担持させて抗菌性を付与する抗菌性CNFはありましたが、CNFそのものに抗菌性があることを確認したのはステラファインが初めてとなります。
・粘度が高いにも関わらずチキソトロピー性(※1)を有する
・保水・保湿性が高い
・分散性が良い
・繊維幅が約3nmと非常に細かく均一
・有機溶媒などと一切使用しない完全水系で製造
・天然素材由来でサステナブルなマテリアル
(薬剤無添加の状態で提供できる)
・保管方法にも自由度がある
※ステラファインを添加した混合物や最終製品の抗菌性を保証するものではありません
丸住製紙では2021年のCNF開発センター創設以降、生産技術の確立を図るとともに事業化に向けて幅広く用途開発を進めています。引き続き、ステラファインの更なる研究・開発を進め、新たな可能性の探求を続けてまいります。
(※1)一定の力を加えるとその瞬間のみ粘度が低下し液状になる性質。力から開放されると粘度はもとに戻る。
これまでに銀イオンや銅イオンなどを担持させて抗菌性を付与する抗菌性CNFはありましたが、CNFそのものに抗菌性があることを確認したのはステラファインが初めてとなります。
- ステラファインの特徴

・粘度が高いにも関わらずチキソトロピー性(※1)を有する
・保水・保湿性が高い
・分散性が良い
・繊維幅が約3nmと非常に細かく均一
・有機溶媒などと一切使用しない完全水系で製造
・天然素材由来でサステナブルなマテリアル
- 抗菌性の実験
- 「抗菌性」を持つメリット
(薬剤無添加の状態で提供できる)
- ステラファインを使用する側のメリット
・保管方法にも自由度がある
※ステラファインを添加した混合物や最終製品の抗菌性を保証するものではありません
- 今後の展開
丸住製紙では2021年のCNF開発センター創設以降、生産技術の確立を図るとともに事業化に向けて幅広く用途開発を進めています。引き続き、ステラファインの更なる研究・開発を進め、新たな可能性の探求を続けてまいります。
(※1)一定の力を加えるとその瞬間のみ粘度が低下し液状になる性質。力から開放されると粘度はもとに戻る。
このプレスリリースには、メディア関係者向けの情報があります
メディアユーザーログイン既に登録済みの方はこちら
メディアユーザー登録を行うと、企業担当者の連絡先や、イベント・記者会見の情報など様々な特記情報を閲覧できます。※内容はプレスリリースにより異なります。
すべての画像
